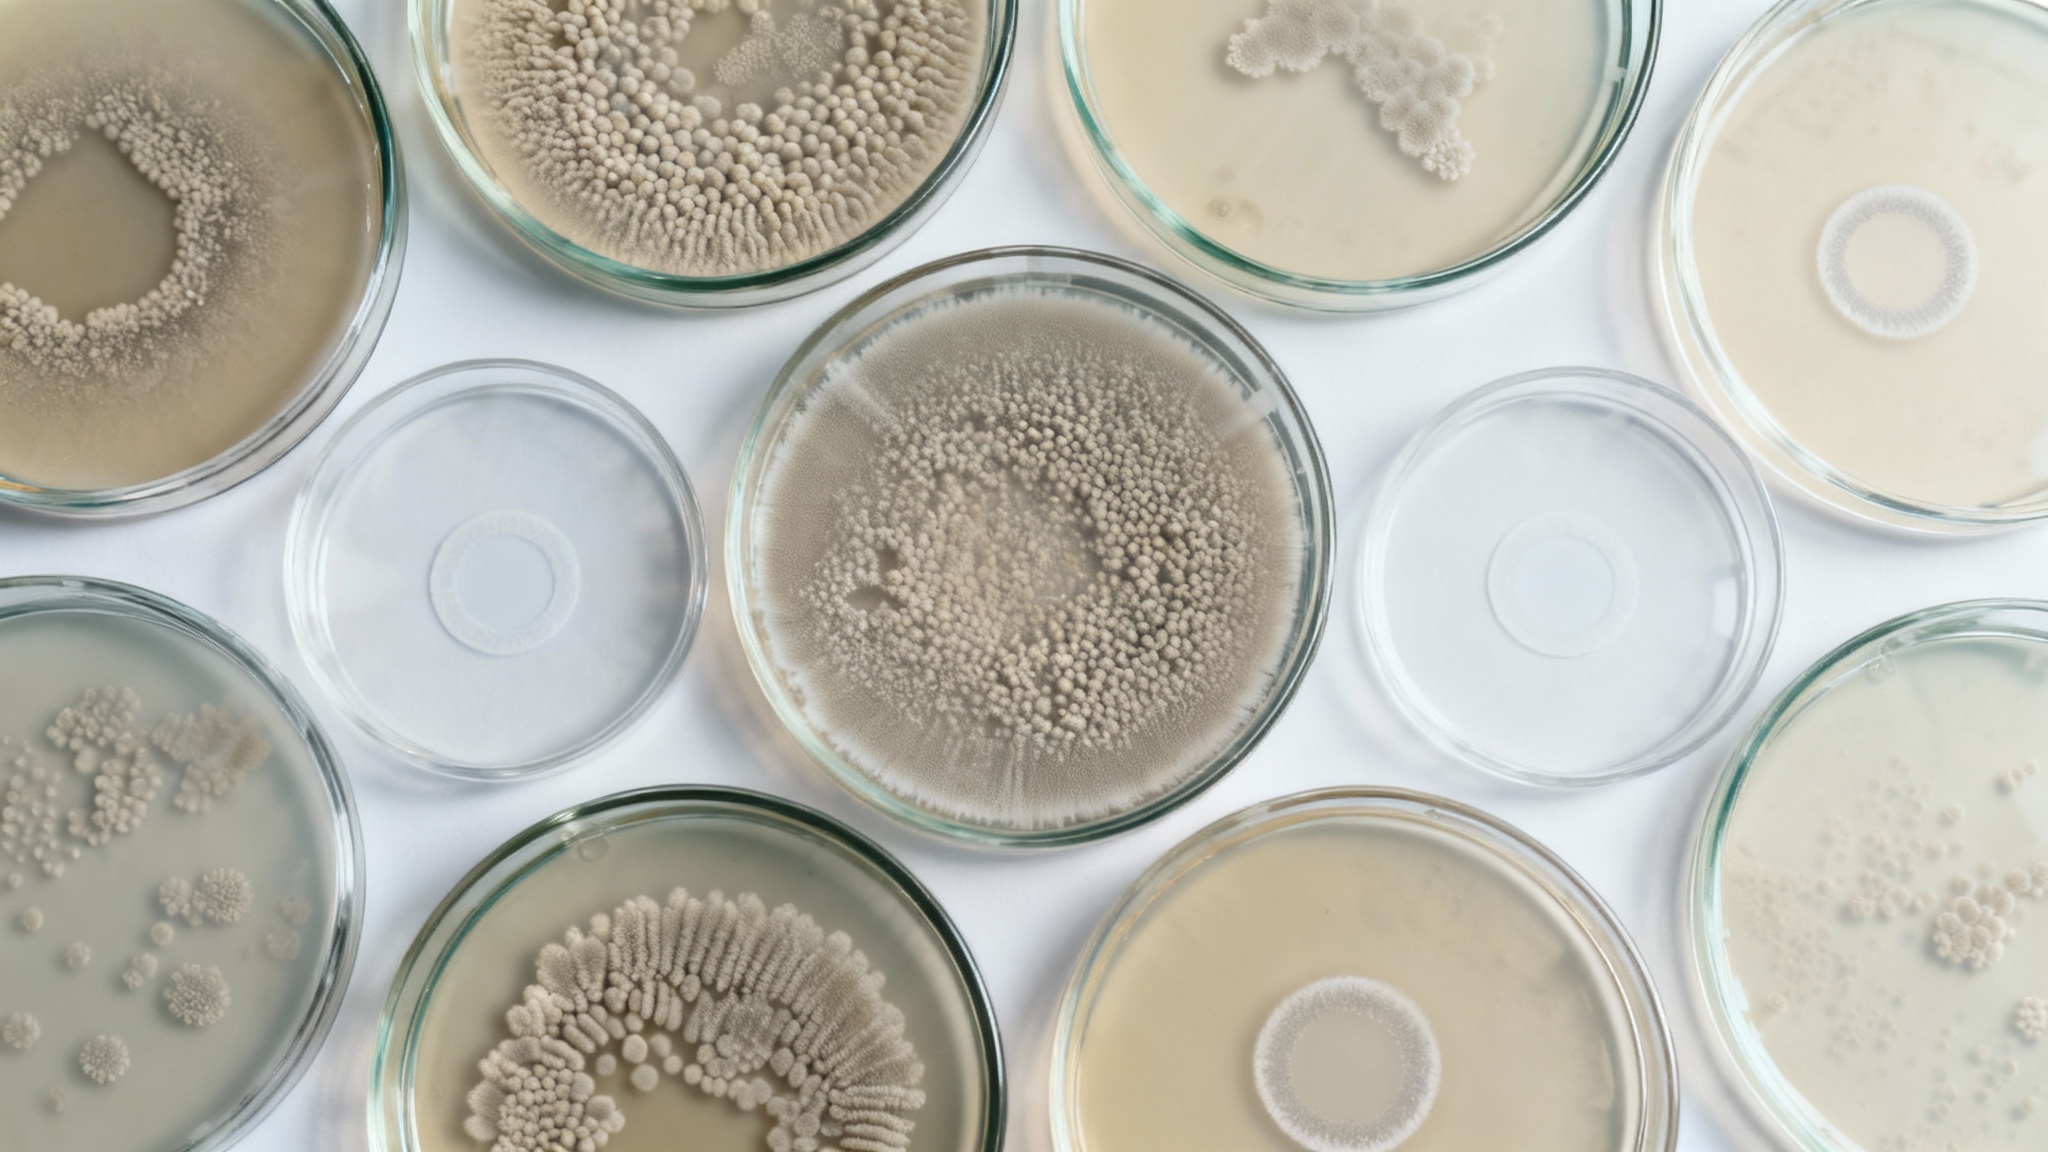
Des résultats qui changent la donne

Une maladie silencieuse mais tenace

La clé : démanteler l'armure de la bactérie

Une précision chirurgicale grâce à une chimie nobélisée

Des résultats qui changent la donne
Conclusion : bien plus qu'un simple médicament

Selon la source : science-et-vie.com










